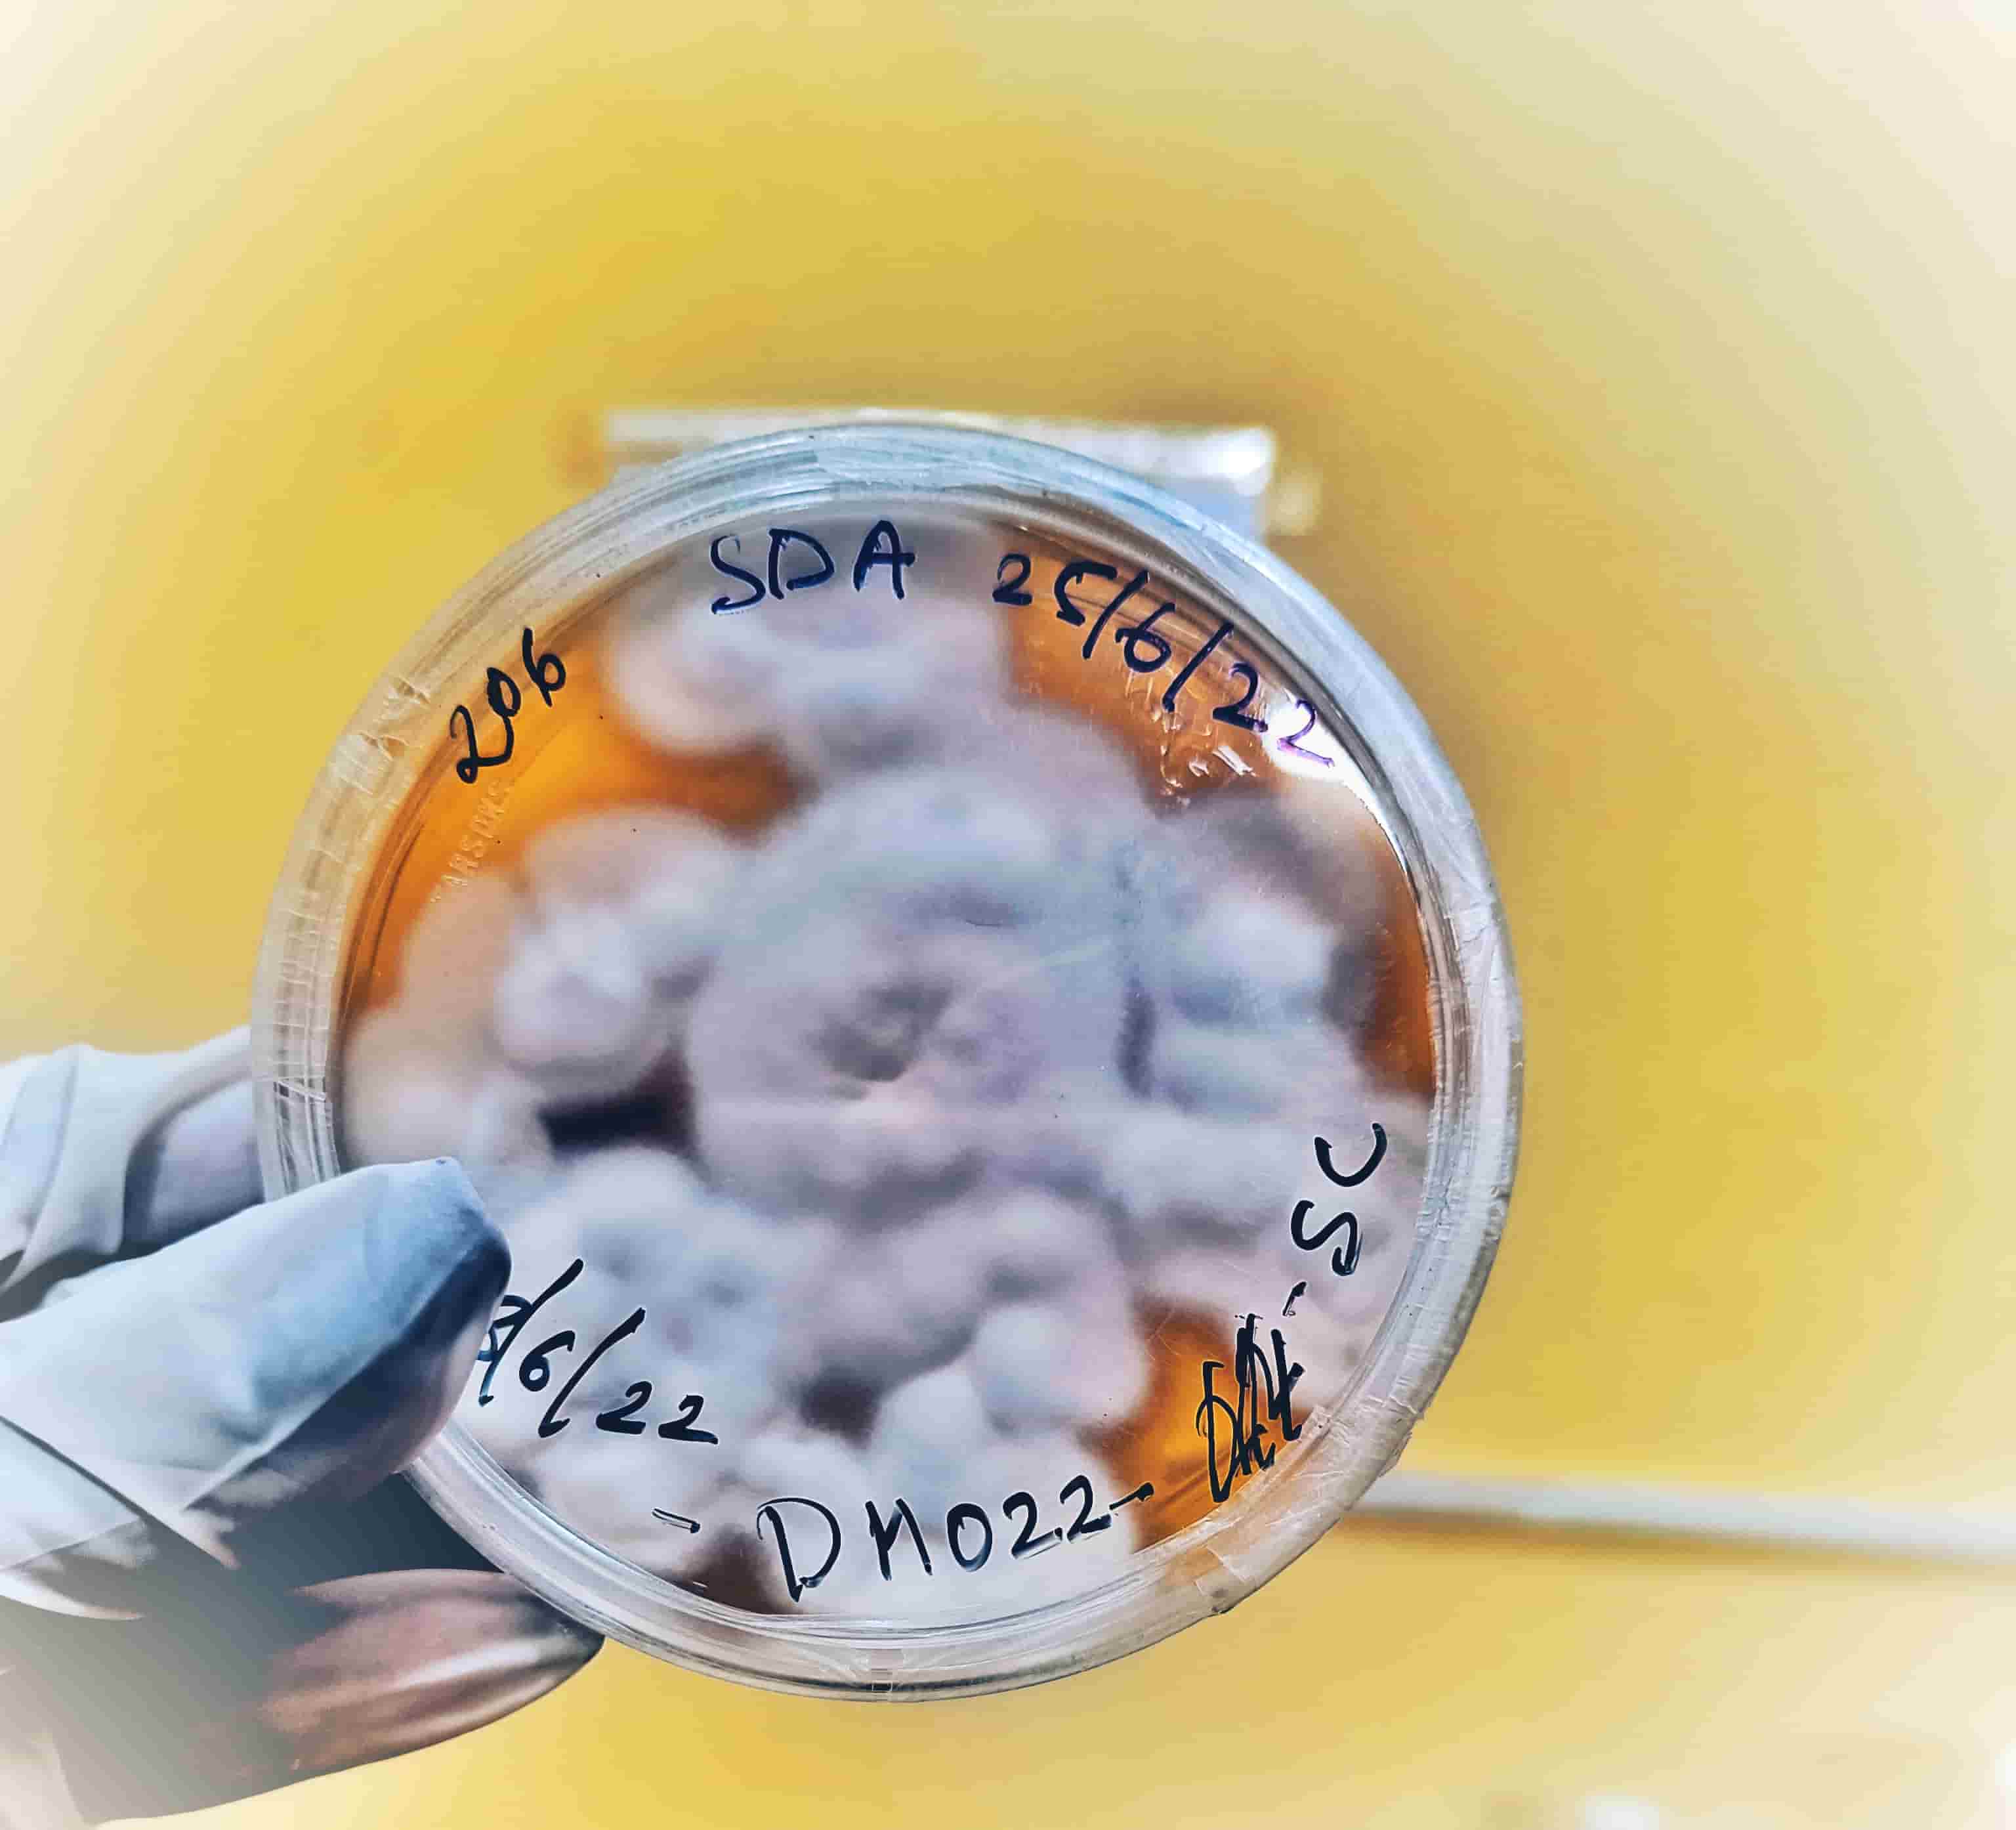
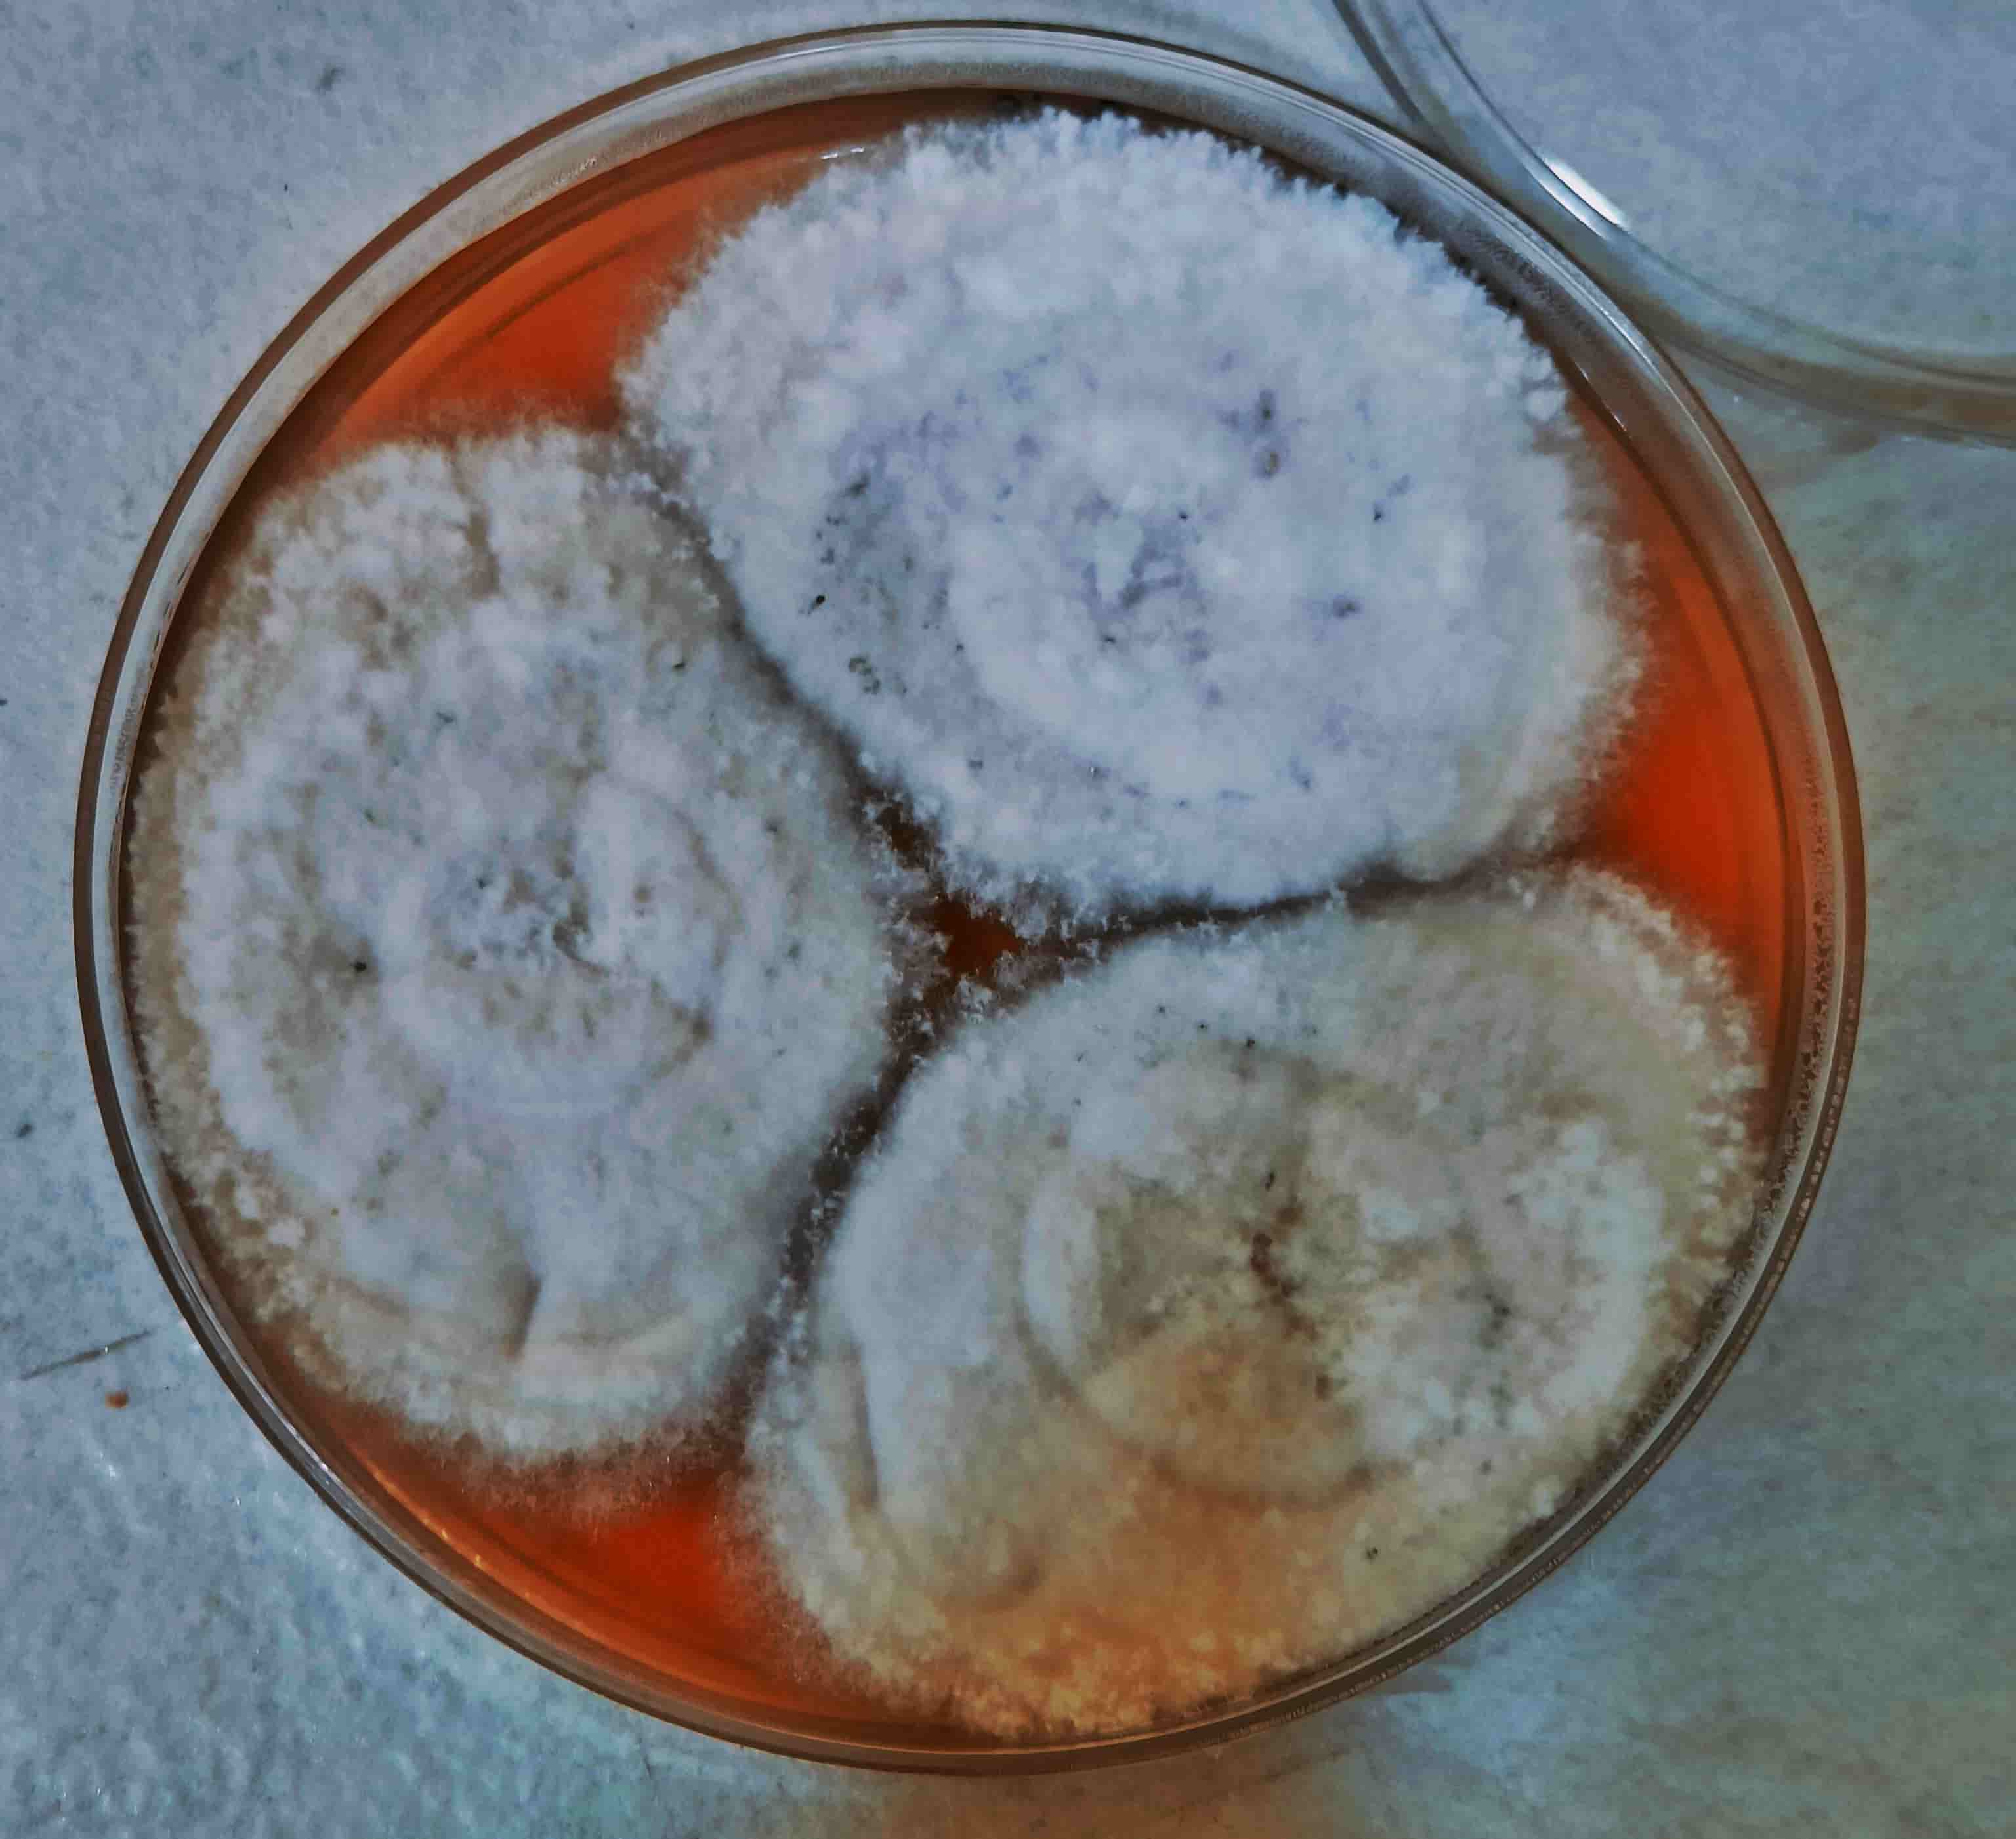
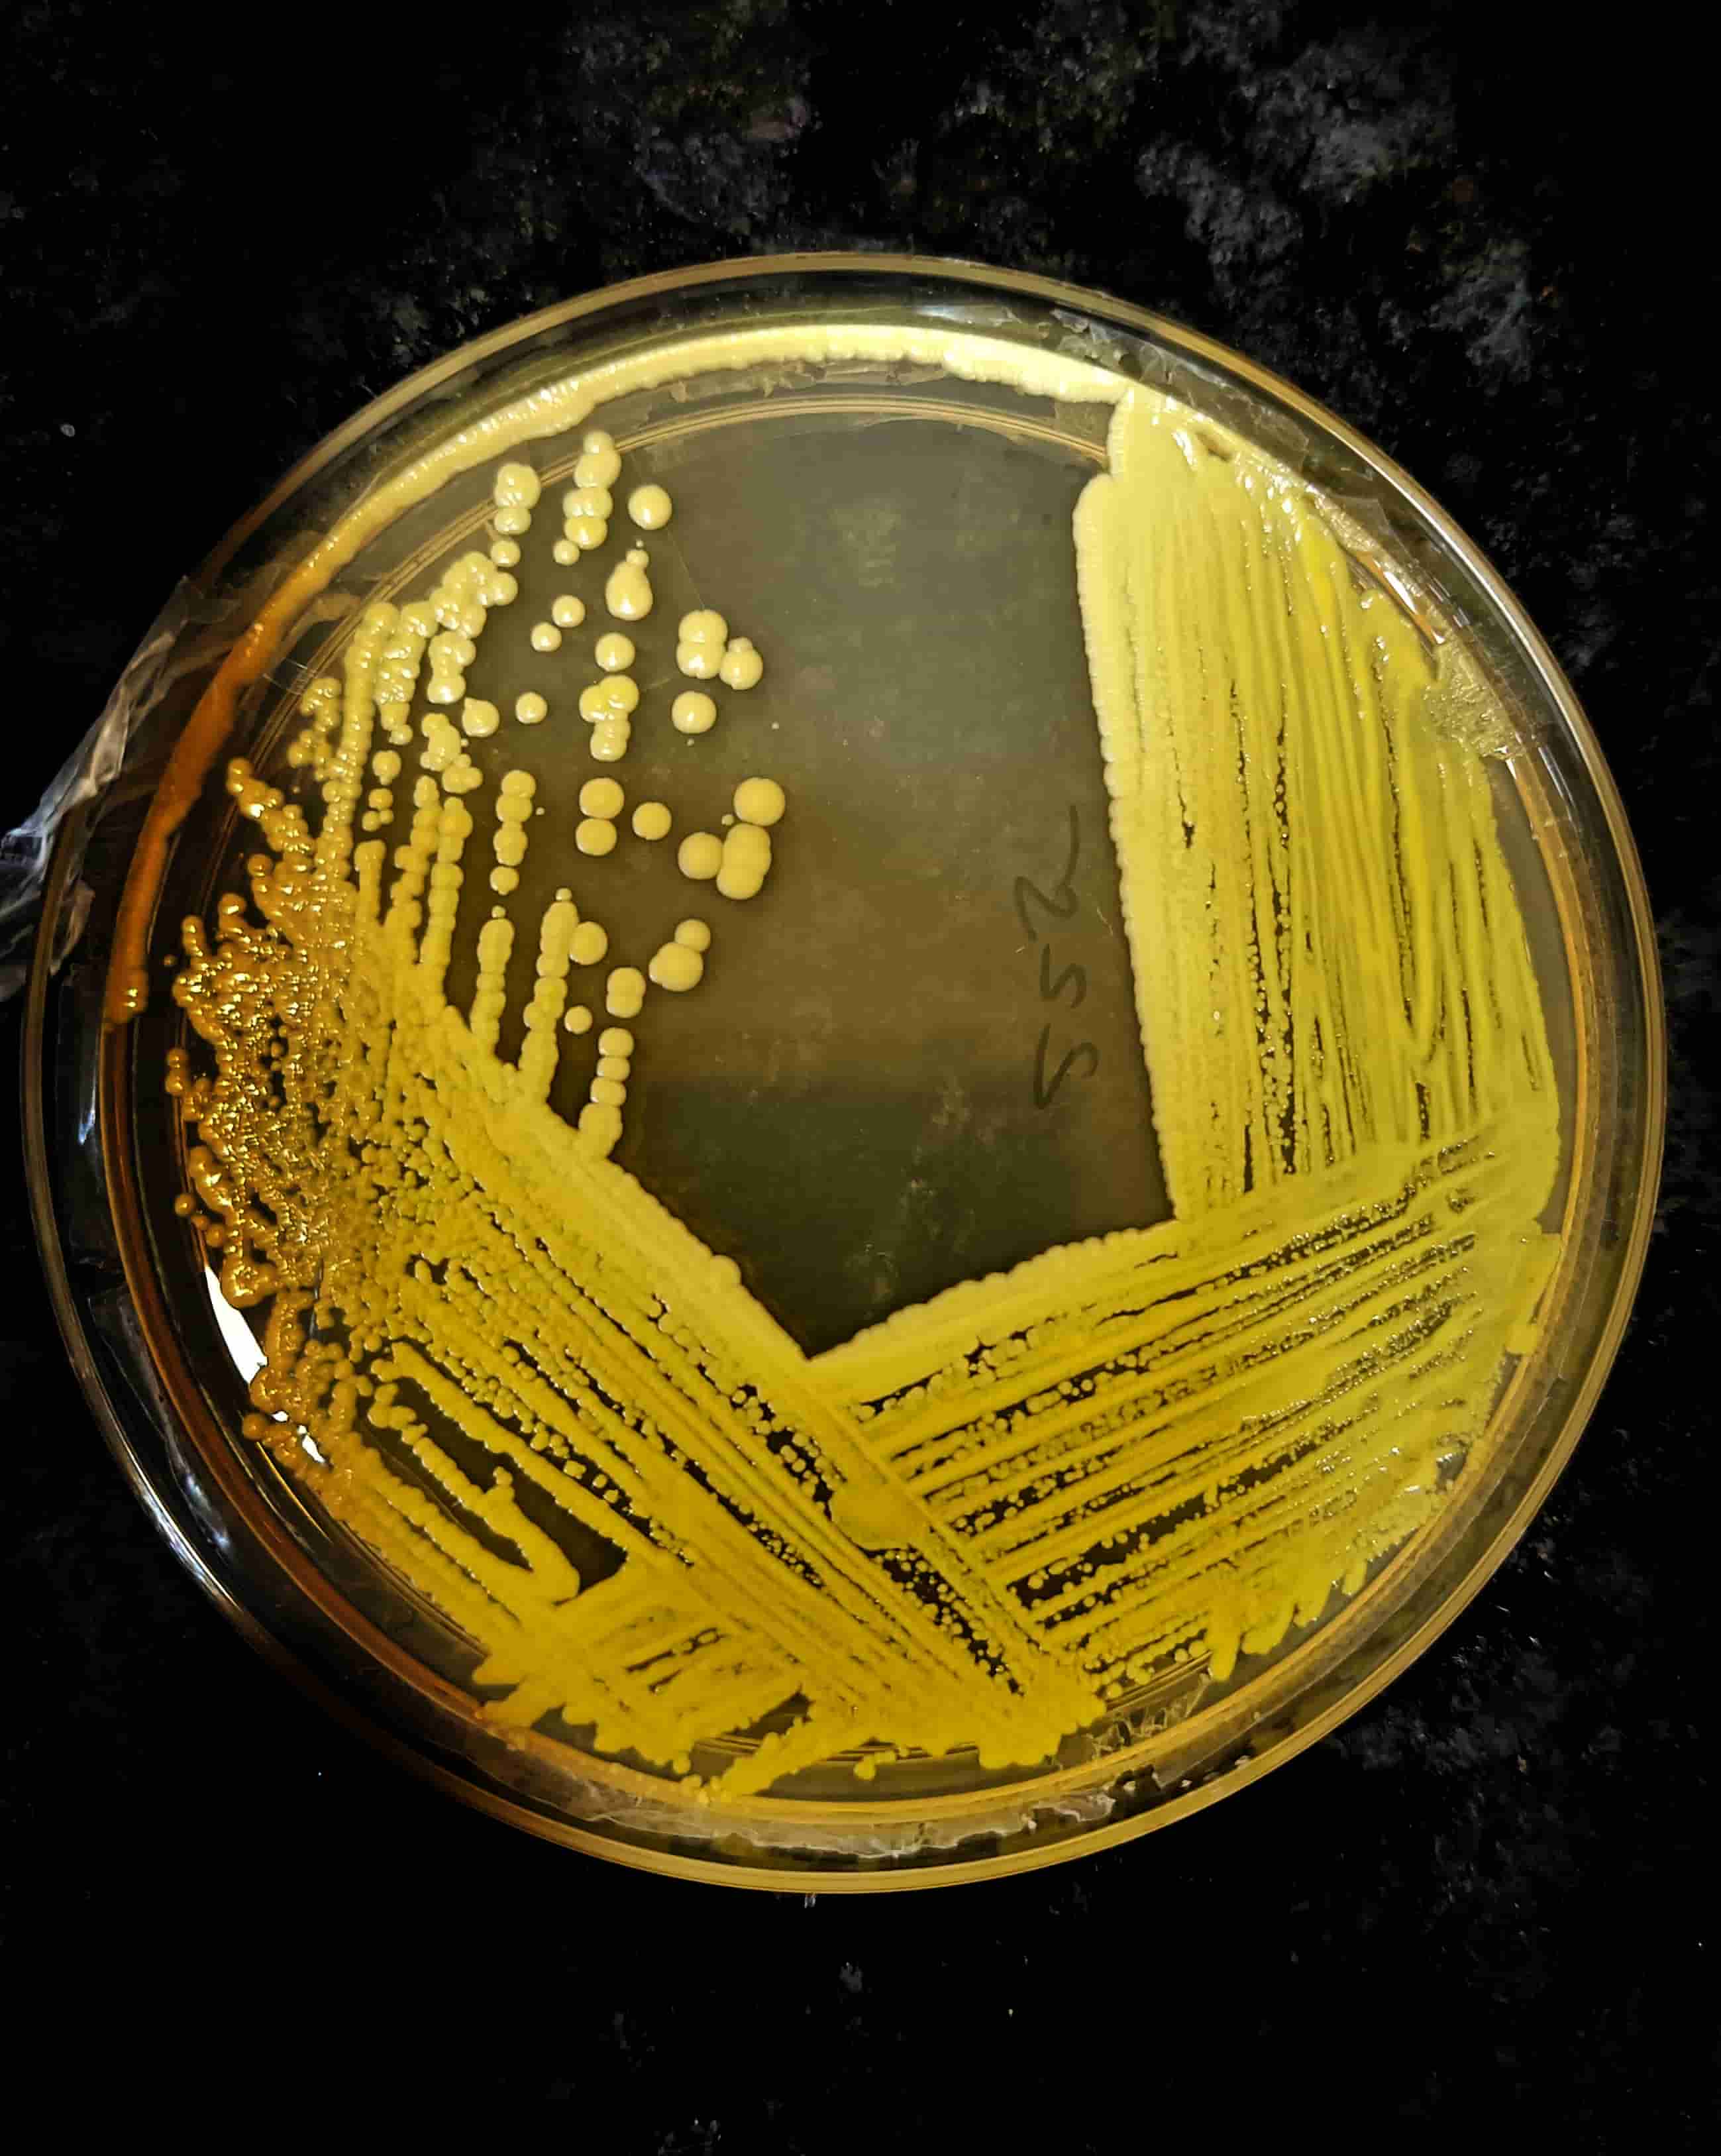

Dr. Gopal Purohit holds a PhD in Biotechnology from Kalinga Institute Of Industrial Technology (KIIT) and MSc from Berhampur University (BU) with an illustrious professional experience of more than a decade in the field of Clinical Genomics and Infertility Research.
Dr. Gopal Purohit has over 10 years of experience in the areas of Lifesciences Services & Training and 5 years experience heads the company’s operations in the position of a CEO, focusing on planning and conducting day-to-day research activities, resolving procedural/ logistical problems as appropriate to the timely completion of research objectives. He’s also involved in organizing various training programs in the field of Clinical Genomics, Infertility….
He has more than 40 national and international publications of peer-reviewed journals to his credit; He also has an approved patent to his credit for IoT-based automatic brain tumor detection system. He is a visionary bioclinical scientist with a goal to establish the company’s presence across the globe with a large portfolio of Life science services and training.

Mr. Swadhin Palo holds a Master’s degree in Biotechnology from Berhampur University, Odisha. He has over 10 years of experience in the Life sciences industry.
Currently, Mr. Swadhin manages the Financial Planning and Marketing/Sales portfolio in the position of a COO, responsible for business development, creating marketing strategies for market penetration, charting the business growth prospects, development of marketing and sales functions along with financial planning for growth of the company.
Mr. Swadhin has been the strong pillar of Heredity Biosciences, responsible to establish the network of dealers and clients across the country with the zeal to create maximum scientific impact through superior quality Lifesciences services, globally.

Metabolome means the complete set of small-molecule chemicals found within a biological sample and Metabolomics refers to the systematic identification and quantification of the metabolome of a biological system at a specific point in time. In metabolomics, metabolites and their concentrations directly reflect underlying biochemical activity and state of cells or tissues. For metabolome profiling, mass spectrometry is the most commonly used techniques.
The compounds which can be tested at Heredity Biosciences are widely covered, ranging from small water-soluble molecules to large lipids. We can analyze a variety of biological materials, including but not limited to biofluids and tissues from animals, cell cultures and humans
Our experts with years of experience in metabolomics, bioinformatics, statistics and various application fields can help you plan, conduct, and report your metabolomics studies. Whether you want to study the whole metabolome, or just a few metabolites or pathways, we will closely work with you to define research purpose and develop customized plans.

Also called as discovery metabolomics, this method is used for the identification and quantification of detectable metabolites of control and test groups which are compared to identify differences between their metabolite profiles.
This is a quantitative method for the identification and quantitative analysis of targeted metabolic compounds in organisms. We can provide a wide range of targeted metabolomics services, including targeted metabolic pathways, targeted metabolites analysis, plant metabolites analysis, organic compounds analysis, etc.
This methodology is used to identify unknown metabolites, to provide accurate information like retention time, mass spectra, determination of the molecular mass and the elemental composition of the compound, etc. Combining this information with various algorithms, we can determine the identity of the compound.
Register Address
818, Mayfair Lagoon Road, Jayadev vihar, Bhubaneswar-751013
Email Id:
info@hereditybio.in
Mob No:
:+91 73812 98980
© 2025, Heridity Biosciences. All Rights Reserved.| Design & Developed by : Malus TechnoLab




